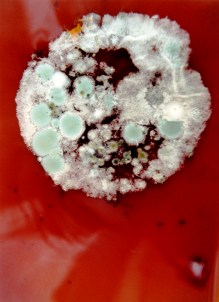
Bad Moon Rising (1998)

>
Naomi Foyle / Seoul Survivors
>
>
Naomi Foyle Seoul Survivors (Jo Fletcher Books 2013)
ISBN 9781780875989
>
The dark cyber-thriller Seoul Survivors is the debut novel from poet, performer and activist Naomi Foyle. Published by Jo Fletcher Books (an imprint of Quercus) on 28th February 2013.
‘A meteor known as Lucifer’s Hammer is about to wreak destruction on the earth, and with the end of the world imminent, there is only one safe place to be.
In the mountains above Seoul, American-Korean bio-engineer Dr Kim Da Mi thinks she has found the perfect solution to save the human race. But her methods are strange and her business partner, Johnny Sandman, is not exactly the type of person anyone would want to mix with.
Drawn in by their smiles and pretty promises, Sydney – a Canadian model trying to escape an unhappy past – is an integral part of their scheme, until she realises that the quest for perfection comes at an impossible price.’
>
Naomi Foyle (2008)
john luke chapman
official author portrait for Jo Fletcher Books
>